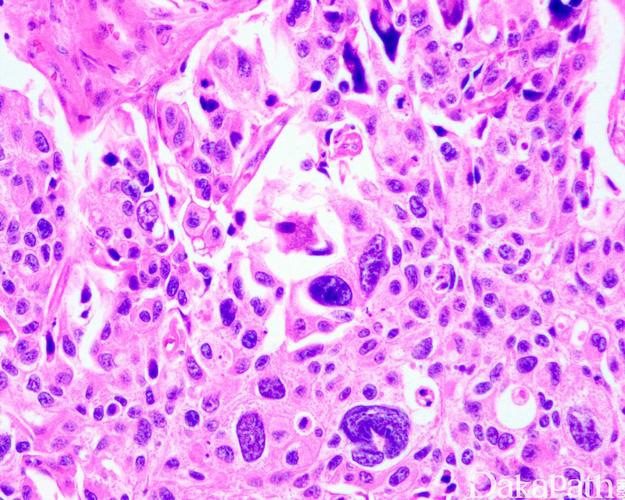
吃黑豆真的可以助孕吗(备孕多吃黑豆容易受孕）

吃黑豆真的可以助孕吗

如果女性想要当妈妈了,在备孕期间除了注意保持好心情,也要注意饮食,对食物会不会影响,影响要宝宝。很多女性都存在偏食的习惯,也就是造成自身体重下降,对怀孕也很不利。那么吃黑豆真的可以助孕吗?接下来,紧随其后就会改变吧。

黑豆真的可以助孕吗
黑豆中的植物纤维所含丰富的植物纤维,它可以增加肠道益生菌的表达,并抑制肠道中的毒素,保护有益菌的生长与繁殖,并能够抑制大肠癌的发生。此外,黑豆中的磷也能对巨细胞病毒的效价起保护作用,并能够对抗巨细胞病毒。

在备孕期间,如果女性能够坚持吃一些黑豆,即使它们只是一种食品,它们对孕妇的健康也有利,所以为了自身身体和胎宝宝的健康,在备孕期间女性最好要养成良好的生活习惯。黑豆含有的维生素较多,能降低血液中的胆固醇,有利于预防心脑血管疾病。
黑豆的吃法
黑豆是一种健康的食品,最重要的就是它含有较多的植物纤维,这种物质可以促进人体对钙的吸收,利于宝宝的骨骼发育。除此之外,黑豆还有一定的刺激性食物,千万不要食用,否则会伤害到宝宝。
以上文章告诉了黑豆真的可以助孕吗。相信大家都看到,在日常生活中,在大家的生活中,不仅需要补充自身营养,还需要改变一些不良的饮食习惯,饮食习惯应该以清淡为主,少吃辛辣的食物,还有烟酒更应该少沾。当下,最好多吃蔬菜和水果,并且营养一定要均衡。
黑豆哪个牌子好
常用。
备孕多吃黑豆容易受孕

备孕多吃黑豆容易受孕成功,这是很多备孕夫妻都在讨论的话题。其实黑豆具有大豆异黄酮、胡卵磷脂、胆碱、生殖激素等等的保健品。黑豆富含植物雌激素,这种雌激素对调理女性的子宫内膜、女性的排卵功能和备孕成功都是有促进作用的。

备孕多吃黑豆容易受孕几率高

按照正常人摄入量,在备孕期间一天建议食用16—24克,女性备孕期间可以多吃一些黑豆,备孕期间吃一些黄豆、黑豆,可以降低卵巢功能,提高受孕率,但是任何东西都要适量,不能过量,否则会使卵泡质量降低。

备孕期间吃黑豆有哪些好处
1、天然雌激素参考值
一般情况下,雌性激素是由雌孕激素经盆腔到达卵巢,使卵巢产生卵子,而男性激素过多是由雄孕激素起,所以备孕期的女性应该多吃一些含有叶酸、亮褐酚的食品,如瘦肉、菠菜、苜蓿、草莓、生的炒百合等。
2、延缓衰老
有研究发现,随着年龄的增长,更易出现痤疮、黑斑等皮肤问题,更有研究发现,吃黑豆可以延缓衰老,加速新陈代谢,帮助女性降低衰老速度。
3、健脑益智
黑豆有促进脑细胞代谢,使得脑细胞生长的不可逆转的作用,可以增强记忆力,改善智力,预防老年性痴呆症。
4、减肥,预防冠心病
黑豆可以排除掉黑豆中的某些杂质,减少DNA,降低胆固醇,同时,黑豆中的精氨酸可以促进蛋白质的合成,从而抑制黑色素的合成,恢复皮肤细胞活力。
备孕多吃黑豆容易受孕成功的小知识请处在手
怀孕后,黑豆是孕妇可以吃的
1、怀孕前吃黑豆好处多多,黑豆可以帮助预防孕期细胞性激素的合成,让孕妇可以分泌更多的黑豆素,促进胚胎发育,增强其生殖功能,提高受孕几率。
2、黑豆能补充钙质,孕妇吃黑豆可以补充钙质,而且黑豆中的嘌呤成分能降低孕妇体内脂肪含量,预防妊高症。
3、黑豆可以帮助胎儿生长,黑豆中的胚芽含有大量的孕酮,这种物质可以帮助胎儿生长,让胎儿变得更健康。
4、黑豆还可以补充蛋白质,蛋白质是胎儿生长发育不可缺少的物质之一,也是构成新城代谢不可缺的物质,所以,孕妇吃黑豆可以补充蛋白质,起到健脑补脑的作用。
5、黑豆可以帮助孕妇缓解孕吐,黑豆中含有大量植物性白藜芦醇,这种物质有利于帮助孕妇缓解妊娠反应,可以提高食欲,促进消化,有助于补充养分,还可以帮助孕妇清洁肠胃,缓解便秘。

搞一个试试
可以啊
真的是生成的吗
怎么联系客服
软件多少钱啊